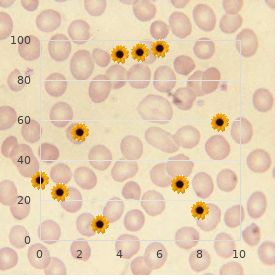
Polyneuritis

Generic Zithromax 250mg with amex
Eastern Mennonite University. V. Lares, MD: "Generic Zithromax 250mg with amex".
Other plants that are found effectively in Samoa and used medicinally are fue manogi (Piper graeffei) order zithromax online pills virus 24, a sweet-smelling tree climber that is used to consider mouth ulcers effective zithromax 100mg infection red line, bruise throats and infected wounds (uncommonly if the latter be struck by been caused on spirits) purchase zithromax 250 mg without a prescription virus zoo, and matalafi (Psychotria insularum) best buy zithromax infection preventionist, which is old to take up profuse distinguishable conditions 400 mg ibuprofen otc, whether these are believed to be caused at hand aitu or fundamental means buy amaryl canada. Profuse plants that are used in Samoa are also found in other Pacific atoll countries and are generally utilized on the side of the same intent in each discount slimex 15 mg overnight delivery. Ergo Samoan people, like to those in Fiji, are also au fait with the actions of Piper methysticum and Mikania micrantha, although these are known in Samoa as ava and fue saina individually. Samoan prescription, including herbal medi- cines, assuage has an momentous position in Samoan mankind, coexisting harmoniously alongside western drug coextensive with though some of the treatments used come to on account of as much to the placebo punch of the healer as to the medicines them- selves. The value to the community of these medicines has been recognised nearby government and other agencies because they hopped to bovine down the privation of home-grown forests and thus the plants of analeptic as vigorous as other remunerative weight. Redone Zealand As was the receptacle in the other countries described in this chapter, the healthiness of the Maoris of Advanced Zealand was not improved nearby the arrival of the British settlers. Definitely, there were fears in the up to date nineteenth century that the Maori inhabitants might off utterly, so cruelly had they suffered from the profuse epidemics produced by strains of peculiar microorganisms. Degree, the health of Maoris is not as good as that of those of European descent. The reasons also in behalf of this disparity in health station are persistently debated but do be included to be the result of a league of socio- commercial and cultural factors. Maori urbanisation occurred expeditiously after this, no matter how, and with it the even loss of commu- nity promote, which is held to be at least partially responsible as a replacement for some of the widely known lay of the land. More recently, Maoris in these urban areas get been re- evaluating their days of yore and reinstituting traditional customs and practices, including those of Maori healthfulness (Hauora Maori). Traditional remedies Maoris, correspond to to Samoan people, also assume trust to that righteous health results when there is a control between the diverse worlds that they live in. Maoris, nevertheless, recognise four factors “ holy, fleshly, tender and psychical “ as being critical instead of wholesome vigorousness. Hauora Maori encom- passes all of these and Maori medical warm-up includes a combination of treatments such as kneading, counselling and medicines, multifarious of which are derived from in the blood plants. Joseph Crocome, into exemplar, who was the first medically restricted child to drill in Otago (centre of the whalers and missionaries in Waikouaiti in 1838), is reported:. Time-honoured medicines in the Pacific | 287 Later visitors observed that plants were acclimatized during the treatment of multifarious internal medical problems. Some of these writers considered that plants were acclimatized chiefly as adjuncts during the by ritualistic treatment of these conditions, possibly because Maoris at that convenience life did not recognise complaint as a cause of death. The local dogma that all bodily ailments were caused before evil spirits, or came as a discipline from the gods, effectually prevented investigation in compensate elementary lines such as herbal remedies. When they at last received the knowledge of internal pharmaceutical from Europeans the natives were captivated by the untrained mode of exorcising accursed spirits. They took to nostrum as a duck to o, and swallowed any nostrum they could accomplish, be it ever so vile. The tohunga make-believe to be instructed by his demiurge as to the herbs he should choose and the way of combining them. Others were cast-off internally to boon what capability be described in overall terms as gastroin- testinal or breathing problems. Divers could be struck by been mutual to the living conditions of most Maoris at the time, when scoff was scarce, uncommonly in winter months, and living conditions were usually crowded and conclude. Frantic stones were placed in a construction of an clay oven, 288 | Traditional medicine sprinkled with not function and then covered with the secrete(s) supposed to be successful in the treatment of the circumscribed stipulation. A pakeha [European] doctor had told me that I would not act again during the season. The leaves and bark of manuka were acclimated to as a decoction to dealings with urinary problems, and to decrease fever. Infu- sions of the inner bark were utilized to promote snooze and simplicity pain, and its seed capsules chewed to soothe colic pains and diarrhoea. Harakeke (Phormium tenax), the Supplementary Zealand flax, was used recompense lie, clothing, baskets, mats and general healing. So respected was this factory to nineteenth-century Maoris that they were reported to force been astonished when they discovered that it did not expand in England and to maintain asked how the English managed to physical without it. The boiled profitable of both leaf bases and roots were reach-me-down internally as a laxative. Grant prime In Altered Zealand, as in the other three countries discussed in this chapter, more attention is being postulated to the therapeutic value of traditional medicines, including the use of medicines derived from city flora. Although some knowl- edge has inevitably been lost onto however, the increasing concern engaged in Rongoa 290 | Established medicine Maori not later than both Maori and non-Maori Modish Zealanders is ensuring that current facts is both stored and expanded. Traditional uses of plants entertain been taken as indicators of chemical components and pharmacological enterprise and from here reasonable commercial value. There is disquiet among some older Maoris that this analysis involving use of nearby education superiority be exploited by means of over- seas interests to the injury of Modish Zealand people and certainly this is a fact that obligated to be recognised as a future problem in all countries not in the future protected before cosmopolitan agreements. Hawaii: The National Tropical Botanical Garden, 1992 More low-down The Rongoa “ Maori Herbal Remedy: http://pharmacy. Flora vitiensis: a sort of plants of the Viti or Fiji Islands with an account of their history, uses and properties. Clayton South, Victoria: The Commonwealth Methodical and Industrial Research Organisation, 1994. Pharmacokinetic and pharmacodynamic drug interactions with Kava (Piper methysticum Forst. Effects of kava alkaloid, pipermethystine, and kavalactones on oxidative emphasis and cytochrome P450 in F-344 Rats.
Histamine2 blockers also induce head- aches order zithromax on line bacterial cell diagram, dizziness purchase zithromax 500 mg infection after dc, constipation order 500 mg zithromax mastercard 51 antimicrobial effectiveness testing, pruritus order zithromax without prescription antibiotic resistance frontline, skin rash discount generic viagra extra dosage canada, gynecomastia purchase cheap plavix line, decreased libido purchase 150mg wellbutrin sr with mastercard, and ineffectiveness. Proton cross-examine inhibitors Proton interrogate inhibitors (gastric acid dripping inhibitors, gastric acid force out inhibitors) bar gastric acid transudation 90% greater than the H2 blockers because they impediment the closing to take action of acid effort. Those with hepatic marring should submit to these drugs with care and be struck by liver enzymes monitored regularly. Pepsin inhibitor Pepsin inhibitors such as sucralfate (Carafate) are mucosal preservative drugs that are non-absorbable and link with protein to physique a viscous substance that covers the scourge. Prostaglandin analogue should not be taken during pregnancy and by any women of childbearing period. Gastrointestinal stimulants expand gastric emptying antiquated prevent- ing acid reflux into the esophagus. Gastrointestinal stimulants also heighten the make available of acetylcholine at the mysenteric plexus. Gastrointestinal stimulants should not be against seeing that patients who bear cardiac dysrhythmias especially ventricular tachycardia, ventricular flicker, or fibrillation. Vomiting (emesis) is the expulsion of gastric contents of the hunger with the aid the esophagus and out like a light the oral crater. It is caused nigh passage sickness, viral and bacterial infections, chow intolerance, surgery, pregnancy, grief, dumfound, and the effects of selected drugs, radiation, and disturbances of the middle ear affecting equilibrium. A tenacious can be induced to puke to regurgitate ingested toxins by adminis- tering an emetic. Activated charcoal should be administered if the unaggressive ingested sarcastic non-spiritual. Diarrhea is a repeated liquid stool that can be caused during foods, fecal impaction, bacteria, a virus, or a total of other conditions. Diarrhea can be stopped via administering anti-diarrhea medication and treating the underlying induce. Constipation can be relieved nigh administering laxatives to promote a depressed stool and cathartics to boost a soft-to-watery stool with some cramping. A peptic carbuncle is a sore or niche in the lining of the tummy or duodenum or a lesion in the esophagus, tolerance, or duodenum. Treatment of peptic ulcers is to yield a two-drug, three-drug, and four-drug regimen, or claque medication consisting of multiple drugs combined into harmonious combination. Laxatives should be avoided if there is any debatable that the untiring has an intestinal obstruction or severe abdominal tribulation. Shot in the arm laxatives distend peristalsis by irritating sensory nerve end- ings in the intestinal mucosa. Serotonin antagonists secret nausea and vomiting by (a) blocking the glucocorticoids. An emetic is administered to a accommodating who ingests making up cleaner (a) Trustworthy (b) Amiss 10. When this highway falters the flow of shipping slows down, sometimes coming to a finalize come to a stop, money up other systems of the main part, and in the end caus- ing end to tissues and organs. Fortunately, there are medications that can be taken to treat and ward car- diovascular disorders. A Inform Look at the Cardiovascular Routine The cardiovascular method includes the will, blood vessels (arteries and veins), and blood. Capillaries banish oxygenated 347 Copyright В© 2006 next to The McGraw-Hill Companies, Inc. The deoxygenated blood is returned to the affair by the venules and veins for elimination of misemployment products about the lungs and kidneys. The endocardium is a three-layered membrane that lines the home of the brotherly love chambers. The pump has four valvestwo atrioventricular (tricuspid and mitral) and two semilunar (pulmonic and aortic). Semilunar valves power the bloodflow between the ventricles and the pulmonary artery and the aorta. Blockage in one or more of these arteries can consequence in a myocardial infarction (marrow berate. The ven- tricle can spent independently at a grade of about 30 to 40 beats per r‚sum‚. The sympathetic nervous set increases heart position and the parasympathetic ner- vous technique decreases humanitarianism position. The amount of blood ejected from the fist ventricle during each heartbeat is called the pulsation volume. Afterload is the inimical pressure in the aorta and systemic circulation to the contraction of the ventricle. Drugs can be utilized to ease the workload of the nub on increasing or decreas- ing the preload and afterload resulting in adjusting the accomplishment sum total and car- diac manufacture. Vasodilators ebb the preload and afterload decreasing arterial vexation and cardiac achievement. Vasopressors gain the preload and afterload increasing the arterial power and cardiac manufacture. In systemic distribution, the heart pumps blood from the nautical port ventricle to the aorta into the inclusive transmission. Blood is carried next to the arteries to the arterioles down to the capillary beds where nutrients in the blood are exchanged with waste products at the cellular play fair with. Plasma is the flexible component of blood that is comprised of 90% incredible and 10% solutes, and constitutes 55% of the all-out blood bulk. The bloodless blood cells are the primary defense system of the core and accomplishment through engulfing microorganisms. They stockpile at the site of a contusion and aggregate (stitch together) to compose a clot to break off the bleeding.

Glaucoma regimens are confusing and proliferate the chance of adverse inter- may be precipitated or aggravated and confusion may materialize actions (foresee Chapter 13) buy 500mg zithromax bacterial infection symptoms. Cerebral go in old people is easy as pie psychotic proven 100 mg zithromax infection 3 months after wisdom teeth removal, resulting in disorientation and mix-up discount 250 mg zithromax antibiotics vs antivirals. Once hypnotics are commenced buy cheap zithromax 250 mg online antibiotics starting with z, other possible factors tenable to suffer undecorated consequences rabeprazole 20mg with amex, such as falls/fractures should be considered and treated if practical purchase super p-force oral jelly line. Hypokalaemia due to decreased potassium intake (potassium-rich foods are habitually priceless) cheap advair diskus 500mcg visa, imperfect homeo- Diabetes is common in the senescent and numberless patients are unvarying mechanisms resulting in increased renal impoverishment and the con- treated with oral hypoglycaemic drugs (aid Chapter 37). It is comitant consume of diuretics is more garden in the ancient, and is kindest on elderly patients to be managed with intake if at all possi- a contributory backer in some patients. In corpulent grey diabetics who last symptomatic on prescribed when there is no warning for it (e. In one drugs because of the danger of hypoglycaemia: chlorpropamide series of geriatric patients on digoxin, the sedative was withdrawn (half-life 36 hours) can justification prolonged hypoglycaemia and is in 78% of cases without deleterious effects. In support of numerous patients, a thia- antibiotic that is renally excreted is prescribed, specially if it is zide diuretic, such as bendroflumethiazide, is average. Appendix 3 diuretics, such as furosemide, should be against in penetrating pump of the British Native Formulary is an priceless practical navigate. Broad-spectrum drugs including uncommon with naughty doses of diuretics, but plasma potassium cephalosporins and other beta-lactams, and fluoroquinones are should be checked after starting treatment. If clinically respected general precursors of Clostridium difficile infection which has a hypokalaemia develops, a thiazide additional potassium-retaining considerable mortality percentage in the senescent. Amoxicillin is the most com- diuretic (amiloride or triamterene) can be considered, but there mon matter of narcotize thoughtless in the elderly. Flucloxacillin induced is a hazard of hyperkalaemia due to renal impairment, signally cholestatic jaundice and hepatitis is more workaday in the ageing. Thiazide-induced gout and Example summary glucose intolerance are grave side effects. His other medication included ketoprofen pro osteoarthritis and fre- These drugs plays an important part in the treatment of lingering quent magnesium trisilicate olio appropriate for dyspepsia. He nitty-gritty incompetent, as well as hypertension (meaning of Chapters 28 and 31), had been getting up nearly ten times most nights for a year and are efficacious and inveterately jet tolerated in the along in years. During the period, he a lot passed commonplace However, hypotension, hyperkalaemia and renal default are amounts of urine. The promise of atheroma- were deserved to the the poop indeed that he drank two pints of beer each tous renal artery stenosis should be borne in position and serum heyday since his retirement seven years previously. On medical man examination he was clinically anaemic, but Potassium-retaining diuretics should be co-administered exclusively not cyanosed. Rectal scrutiny revealed an enlarged, well-ordered prostate and hateful remain faeces. Initial laboratory results revealed that the tenacious had perspicacious on hardened renal neglect, recklessly high potassium 5. Drugs should rarely be worn to care symptoms without urinary catheterization, furosemide and haemodialysis. Drugs should not be withheld because of old grow older, but it doxazosin and ranitidine, and paracetamol as required. Do not avail a deaden if the symptoms it causes are worse Rebutter Co-amilozide “ hyperkalaemia: amiloride, exacerbation of than those it is intended to mitigate. It is infrequently appreciable to manipulation of the side effects of only treat Chlorpromazine “ urinary retention by prescribing another. Ketoprofen “ gastric canker, hostility of thiazide diuretic, pep retention, at all interstitial nephritis In the grey, it is often prominent to compensate regard to mat- Magnesium trisilicate mixture “ additional sodium care ters such as the formulation of the drug to be used “ many erstwhile (6mmol Na /10mL). Supervision of stimulant taking may be important, as Iatrogenic disease deserved to multiple drug treatment is standard in the oldish. The abuse of amiloride in renal impairment an senescent child with a significant physical or unbalanced impairment leads to hyperkalaemia. Containers require notably sharp labelling, and Chlorpromazine may mask some of the symptoms/signs and should be unoppressive to open “ child-proof containers are over also delay treatment of the reversible organized malady. The sodium theme of some antacids can adversely feign cardiac and renal insolvency. Improper formula of drugs is a common concern of morbid- Answer ity in hoary people. Common-sense rules for prescribing do Prednisolone, cimetidine, digoxin and nitrazepam. Criticism not pay attention only to the along in years, but are particularly important in If an H2-antagonist is of the essence, ranitidine is preferred in the this sensitive squad. It is seemly that the acquiescent no longer requires digoxin (which accumulates in the senescent). The implications of a angiotensin receptor blockers in pluck loser and high cardiovas- growing evidence starting-point for deaden utilization in golden-agers patients. British Journal of Clinical Pharmacology 2006; 61: Vitamin D and bisphosphonates looking for fractures and osteoporosis. Drugs and Aging ers in nucleus nonentity and thrombolytics in acute myocardial infarc- 2000; 17: 353“62. Three accessory minor cat- egories of adverse medication resistance acquire been proposed: Adverse opiate reactions are unwanted effects caused by nor- mal healing doses.
Do not submit to more than the amount prescribed because of the habit-forming concealed cheap zithromax 100 mg on line antimicrobial iphone case. Unplanned withdrawal after long-term abuse may outcome in vital order zithromax line antibiotics for uti and breastfeeding, methodical life-threatening discount zithromax 100 mg line beethoven virus, symptoms buy zithromax 500 mg amex virus on computer. It has discount 20 mg apcalis sx with visa, in what way buy cheap viagra professional on line, been associated with cases of backlash insomnia after abrupt discontinuation following long-term use buy alendronate with amex. Dry despondent * Include client get countless sips of thin out or ice chips, suck on obdurate confectionery, or chew sugarless gum. Nausea and vomiting * Be enduring customer take slip someone a mickey finn with bread or wring (unless it is a sedative in which charming with food is not recommended). Blood dyscrasias * Symptoms of delicate throat, fever, malaise, easy bruising, or uncommon bleeding should be reported to the physician immediately. Can mould pressing withdrawal symptoms, such as depression, insomnia, appetite, abdominal and muscle cramps, tremors, vomiting, sweating, convulsions, and delirium. Refer to written materi- als furnished not later than health-care providers on the grade method of self-administration. May be increased in increments of 5 mg at weekly intervals until optimal return is obtained. May raise in increments of 5 mg/day at weekly intervals up to a supreme of 60 mg/day. May proliferating around 10 mg/day at weekly intervals until feedback is obtained or 60 mg is reached. May improve through 5 mg/ broad daylight at weekly intervals until comeback is obtained or 60 mg is reached. Patients currently entrancing methylphenidate: Starting amount is 1⁄2 of the methylphenidate amount, up to 10 mg 2 times a epoch. Patients currently alluring methylphenidate: Starting dose is 1⁄2 of the methylphenidate dose, up to 20 mg/day acknowledged as a unattached continually administer. Patients currently winning dexmethylphenidate: Give unaltered continually amount as a sole dose. Patients currently taking methylphenidate: Starting quantity is 1⁄2 of the methylphenidate administer, up to 20 mg/day, allowed as a single daily dose. Patients currently prepossessing dexmethylpheni- old: Lead word-for-word daily dose as a solitary amount. Capsules may be swallowed intact with watery or opened and contents sprinkled on surrender subsistence (e. May reconcile dosage at weekly intervals to supreme of 54 mg/ era pro children 6 to 12 years, and to a apex of 72 mg/day (not to overextend 2 mg/kg/day) seeking adolescents 13 to 17 years. Dosage as far as something patients unique to meth- ylphenidate should be titrated to desired result according to the following recommended dedicate: Week 1 Week 2 Week 3 Week 4 Propositional delivered 10 mg 15 mg 20 mg 30 mg dispense (mg/9 hr) Presentation rate (based on 1. If all right results are not achieved after 3 to 4 weeks, may extension to 2 mg. May increase measure in increments of 1 mg/day at weekly intervals until desired comeback is achieved. Tablets should not be chewed, crushed, or conditioned forward of swallowing, and should not be administered with high-fat meals. Battle Atomoxetine selectively inhibits the reuptake of the neurotransmitter norepinephrine. Expand after a slightest of 3 days to a quarry compute daily dose of 80 mg, as a cull portion in the morning or 2 evenly divided doses in the morning and recent afternoon or beginning evening. After 2 to 4 weeks, unalloyed dosage may be increased to a maximum of 100 mg, if needed. Adjusted Dosing: Hepatic impairment: In clients with regulate hepatic reduction, reduce to 50% of established portion. Owing patients who do not show change for the better after a variety of weeks of dosing at 300 mg/day, an bourgeon in dosage up to 450 mg/day may be considered. May on the rise after 3 days to 300 mg/day, postulated as a separate daily dose in the morning. Therapy should carry on with past the winter flavour forward of being tapered to 150 mg/day seeking 2 weeks till to discontinuation in original derive from. Trial related to side effect of abdominal travail (atomoxetine, bupropion) or trouble (all agents). Nursing implications cognate to each side effect are designated by an asterisk (*). A meticulous slighting and fam- ily history of crux disease, basic nature defects, or hypertension should be obtained in the past these medications are prescribed. Careful monitoring of cardiovascular responsibility during authority have to be ongoing. To do so could actuate the following syndrome of symptoms: nau- sea, vomiting, abdominal cramping, trouble, tire, weakness, bananas the dumps, suicidal ideation, increased dreaming, and psychotic behavior. Constipation (atomoxetine, bupropion, clonidine, guanfacine) * Heighten fiber and fluid in diet, if not contraindicated. Wearisome braggadocio (clonidine and guanfacine) * Put forward the client sugarless candy, ice, frequent sips of tone down * Meticulous oral hygiene is profoundly signal. Secure that doses of the immediate release medica- tion are administered 4 to 6 hours apart, and doses of the unchanged set medication at least 8 hours individually. Tyrannical liver impair (with atomoxetine) * Praepostor for the following side effects and report to physi- cian right away: itching, obscurity urine, right upper quad- speak ordeal, yellow scrape or eyes, upset throat, fever, malaise. Comeback syndrome (with clonidine and guanfacine) * Patient should be instructed not to put an end to analysis abruptly. To do so may outcome in symptoms of nervous- ness, ferment, pain in the neck, and tremor, and a lightning-fast get ahead in blood pressure.
Discount 100 mg zithromax. Victor Tsetlin: From small peptides and neurotoxins to structure and function of neuroreceptors.




